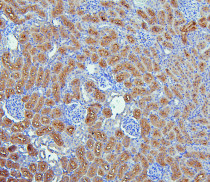

ARG41357
anti-NHERF1 / EBP50 antibody
anti-NHERF1 / EBP50 antibody for IHC-Formalin-fixed paraffin-embedded sections and Human,Mouse,Rat
概述
| 产品描述 | Rabbit Polyclonal antibody recognizes NHERF1 / EBP50 |
|---|---|
| 反应物种 | Hu, Ms, Rat |
| 应用 | IHC-P |
| 宿主 | Rabbit |
| 克隆 | Polyclonal |
| 同位型 | IgG |
| 靶点名称 | NHERF1 / EBP50 |
| 抗原物种 | Human |
| 抗原 | Recombinant protein corresponding to K69-R338 of Human NHERF1 / EBP50. |
| 偶联标记 | Un-conjugated |
| 別名 | EBP50; NHERF; NHERF1; NHERF-1; NPHLOP2; Na(+)/H(+) exchange regulatory cofactor NHE-RF1; NHERF-1; Ezrin-radixin-moesin-binding phosphoprotein 50; EBP50; Regulatory cofactor of Na(+)/H(+) exchanger; Sodium-hydrogen exchanger regulatory factor 1; Solute carrier family 9 isoform A3 regulatory factor 1 |
应用说明
| 应用建议 |
|
||||
|---|---|---|---|---|---|
| 应用说明 | IHC-P: Antigen Retrieval: Heat mediation was performed in Citrate buffer (pH 6.0, epitope retrieval solution) for 20 min. * The dilutions indicate recommended starting dilutions and the optimal dilutions or concentrations should be determined by the scientist. |
||||
| 实际分子量 | ~ 50 kDa |
属性
| 形式 | Liquid |
|---|---|
| 纯化 | Affinity purification with immunogen. |
| 缓冲液 | 0.2% Na2HPO4, 0.9% NaCl, 0.05% Sodium azide and 4% Trehalose. |
| 抗菌剂 | 0.05% Sodium azide |
| 稳定剂 | 4% Trehalose |
| 浓度 | 0.5 mg/ml |
| 存放说明 | For continuous use, store undiluted antibody at 2-8°C for up to a week. For long-term storage, aliquot and store at -20°C or below. Storage in frost free freezers is not recommended. Avoid repeated freeze/thaw cycles. Suggest spin the vial prior to opening. The antibody solution should be gently mixed before use. |
| 注意事项 | For laboratory research only, not for drug, diagnostic or other use. |
生物信息
| 数据库连接 | |
|---|---|
| 基因名称 | SLC9A3R1 |
| 全名 | solute carrier family 9, subfamily A (NHE3, cation proton antiporter 3), member 3 regulator 1 |
| 背景介绍 | This gene encodes a sodium/hydrogen exchanger regulatory cofactor. The protein interacts with and regulates various proteins including the cystic fibrosis transmembrane conductance regulator and G-protein coupled receptors such as the beta2-adrenergic receptor and the parathyroid hormone 1 receptor. The protein also interacts with proteins that function as linkers between integral membrane and cytoskeletal proteins. The protein localizes to actin-rich structures including membrane ruffles, microvilli, and filopodia. Mutations in this gene result in hypophosphatemic nephrolithiasis/osteoporosis type 2, and loss of heterozygosity of this gene is implicated in breast cancer.[provided by RefSeq, Sep 2009] |
| 生物功能 | Scaffold protein that connects plasma membrane proteins with members of the ezrin/moesin/radixin family and thereby helps to link them to the actin cytoskeleton and to regulate their surface expression. Necessary for recycling of internalized ADRB2. Was first known to play a role in the regulation of the activity and subcellular location of SLC9A3. Necessary for cAMP-mediated phosphorylation and inhibition of SLC9A3. May enhance Wnt signaling. May participate in HTR4 targeting to microvilli (By similarity). Involved in the regulation of phosphate reabsorption in the renal proximal tubules. Involved in sperm capacitation. May participate in the regulation of the chloride and bicarbonate homeostasis in spermatozoa. [UniProt] |
| 细胞定位 | Cytoplasm. Apical cell membrane. Endomembrane system; Peripheral membrane protein. Cell projection, filopodium, ruffle, microvillus. Note=Translocates from the cytoplasm to the apical cell membrane in a PODXL-dependent manner. Colocalizes with CFTR at the midpiece of sperm tail. Colocalizes with actin in microvilli-rich apical regions of the syncytiotrophoblast. Found in microvilli, ruffling membrane and filopodia of HeLa cells. Present in lipid rafts of T-cells. [UniProt] |
| 预测分子量 | 39 kDa |
| 翻译后修饰 | Phosphorylated on serine residues. [UniProt] |
检测图片 (5) Click the Picture to Zoom In
-
ARG41357 anti-NHERF1 / EBP50 antibody IHC-P image
Immunohistochemistry: Paraffin-embedded Human lung cancer tissue. Antigen Retrieval: Heat mediation was performed in Citrate buffer (pH 6.0, epitope retrieval solution) for 20 min. The tissue section was blocked with 10% goat serum. The tissue section was then stained with ARG41357 anti-NHERF1 / EBP50 antibody at 1 µg/ml dilution, overnight at 4°C.
-
ARG41357 anti-NHERF1 / EBP50 antibody IHC-P image
Immunohistochemistry: Paraffin-embedded Human mammary cancer tissue. Antigen Retrieval: Heat mediation was performed in Citrate buffer (pH 6.0, epitope retrieval solution) for 20 min. The tissue section was blocked with 10% goat serum. The tissue section was then stained with ARG41357 anti-NHERF1 / EBP50 antibody at 1 µg/ml dilution, overnight at 4°C.
-
ARG41357 anti-NHERF1 / EBP50 antibody IHC-P image
Immunohistochemistry: Paraffin-embedded Human colon cancer tissue. Antigen Retrieval: Heat mediation was performed in Citrate buffer (pH 6.0, epitope retrieval solution) for 20 min. The tissue section was blocked with 10% goat serum. The tissue section was then stained with ARG41357 anti-NHERF1 / EBP50 antibody at 1 µg/ml dilution, overnight at 4°C.
-
ARG41357 anti-NHERF1 / EBP50 antibody IHC-P image
Immunohistochemistry: Paraffin-embedded Mouse kidney tissue. Antigen Retrieval: Heat mediation was performed in Citrate buffer (pH 6.0, epitope retrieval solution) for 20 min. The tissue section was blocked with 10% goat serum. The tissue section was then stained with ARG41357 anti-NHERF1 / EBP50 antibody at 1 µg/ml dilution, overnight at 4°C.
-
ARG41357 anti-NHERF1 / EBP50 antibody IHC-P image
Immunohistochemistry: Paraffin-embedded Rat kidney tissue. Antigen Retrieval: Heat mediation was performed in Citrate buffer (pH 6.0, epitope retrieval solution) for 20 min. The tissue section was blocked with 10% goat serum. The tissue section was then stained with ARG41357 anti-NHERF1 / EBP50 antibody at 1 µg/ml dilution, overnight at 4°C.